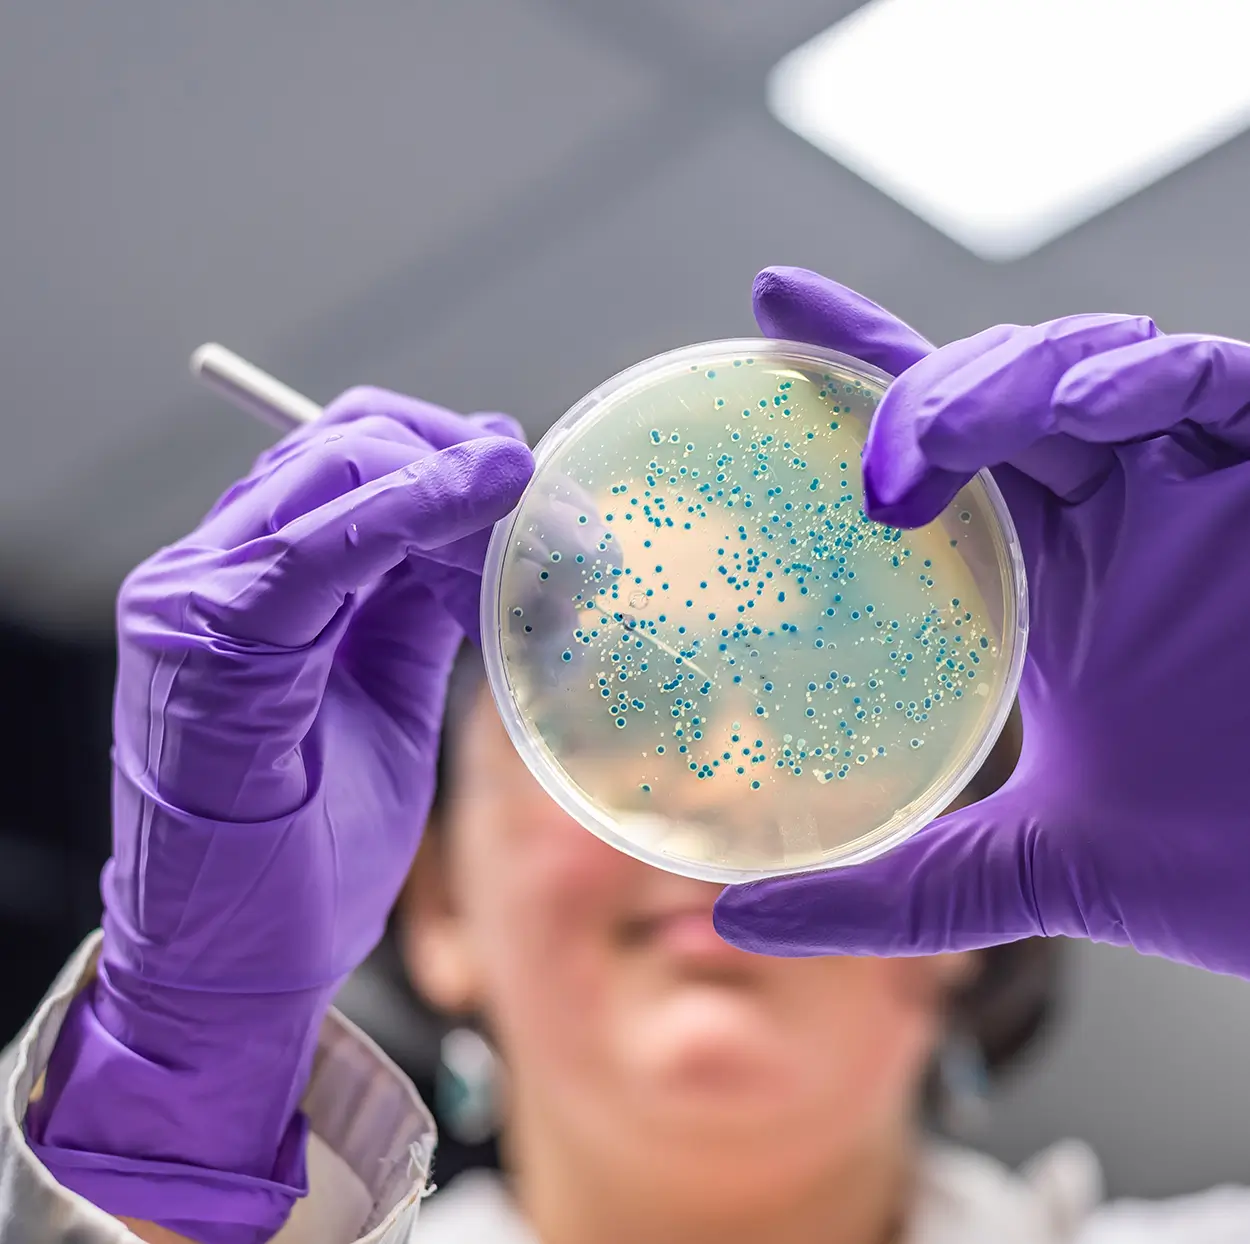

SEQ Laboratories - Environmental Testing Laboratory
NATA Accredited Testing Laboratory
Our NATA accredited laboratory allows us to carry out testing fast and efficiently, reducing the cost to the customer.
An Independent one-stop solution for your AS 5369:2023 testing requirements
For over a decade, SEQ Laboratories has partnered with the Health departments and independent healthcare organizations to deliver exceptional services to decontamination and sterilization departments. As industry leaders in innovation, and continues to expand our range of services, including compliance testing to AS 5369:2023
Committed to impartiality and precise reporting, we prioritize excellent customer service to meet the highest industry standards.